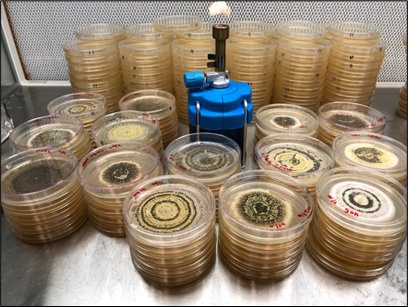
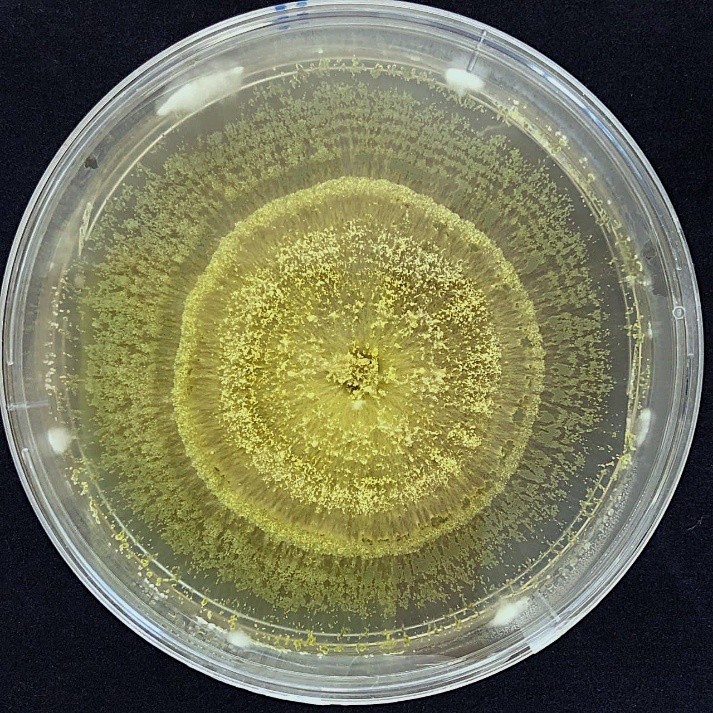

Penulis: Wan Muhammad Azrul bin Wan Azhar
Pegawai Penyelidik, Program Pengurusan Perosak dan Penyakit,
Pusat Penyelidikan Hortikultur, MARDI
Dalam landskap pertanian moden Malaysia, cabaran utama yang dihadapi oleh para petani bukan sekadar faktor perubahan cuaca yang tidak menentu, tetapi juga serangan perosak yang semakin kebal terhadap racun kimia sintetik. Penggunaan racun serangga secara berlebihan bukan sahaja membebankan kos operasi, malah membawa risiko sisa baki toksik yang menjejaskan kesihatan pengguna serta ekosistem tanah. Di tengah-tengah cabaran ini, muncul satu revolusi biologi yang memanfaatkan kekuatan alam semula jadi, iaitu penggunaan kulat Metarhizium. Mikroorganisma ini diiktiraf sebagai agen kawalan biologi yang sangat berkesan, menawarkan cara kawalan perosak secara semula jadi tanpa kesan sampingan kimia yang berbahaya.

Secara biologi, Metarhizium adalah kulat entomopatogen yang bertindak sebagai parasit khusus kepada serangga. Secara mikroskopik, kulat ini mempunyai spora berwarna hijau zaitun yang halus, menyebabkan ia sering digelar sebagai “Kulat Muscardine Hijau”. Apa yang menjadikannya istimewa adalah kewujudannya yang meluas di dalam tanah hutan hujan Malaysia, menjadikannya agen yang sudah sedia serasi dengan iklim tempatan. Berbeza dengan racun kimia yang perlu ditelan oleh serangga atau meresap ke dalam sistem saraf melalui saluran pemakanan, Metarhizium bertindak melalui sentuhan fizikal pada kutikel atau kulit luar serangga, menjadikannya senjata biologi yang sangat unik dan efisien.
Mekanisme serangan Metarhizium merupakan satu proses saintifik yang amat menakjubkan. Segalanya bermula apabila spora kulat, melekat pada badan serangga perosak. Dengan kehadiran kelembapan dan suhu yang sesuai, spora tersebut akan bercambah dan membentuk struktur yang dikenali sebagai appressorium. Struktur inilah yang berfungsi untuk menembusi pertahanan luar serangga. Semasa proses penembusan, kulat akan merembeskan enzim khas seperti protease dan chitinase yang mencairkan kulit keras serangga, membolehkan akar-akar halus kulat menyusup masuk ke dalam badan mangsa.
Sebaik sahaja berada di dalam badan serangga, kulat ini akan membiak dengan sangat pantas dan membebaskan toksin semula jadi seperti destruxin. Toksin ini akan melumpuhkan sistem imun serta merosakkan organ dalaman perosak secara sistematik. Serangga yang dijangkiti biasanya akan berhenti makan dalam tempoh singkat sebelum mati sepenuhnya dalam masa tiga hingga tujuh hari. Bagi petani sayur-sayuran berdaun seperti sawi, kubis, dan kailan, tempoh ini adalah sangat efektif untuk menyelamatkan tanaman daripada kerosakan total. Apa yang menarik, selepas serangga tersebut mati, badan mereka akan diselubungi spora hijau baru yang kemudiannya akan tersebar melalui angin untuk menjangkiti populasi perosak yang lain.

Kajian saintifik di Malaysia kini sedang giat dijalankan untuk mengoptimumkan penggunaan kulat ini. Institusi seperti Institut Penyelidikan dan Kemajuan Pertanian Malaysia (MARDI) dan universiti tempatan seperti UPM dan UKM sedang meneliti keberkesanan pencilan (isolates) Metarhizium tempatan yang bervirulasi tinggi dan lebih sesuai dengan suhu dan persekitaran tempatan. Sebagai contoh, penyelidikan terbaru memfokuskan kepada penggunaan Metarhizium untuk mengawal serangan ulat ratus (Spodoptera frugiperda) pada tanaman jagung dan ulat dari keluarga lepidoptera lain pada sayur-sayuran, yang merupakan ancaman kepada sekuriti makanan negara. Saintis di Malaysia juga sedang bereksperimen dengan formulasi berasaskan emulsi untuk melindungi spora daripada sinaran UV yang tinggi, membolehkan kulat ini bertahan lebih lama apabila disembur di kawasan terbuka. Usaha ini sangat kritikal bagi memastikan petani di kawasan panas di tanah rendah mahupun kawasan sejuk di tanah tinggi seperti Cameron Highlands dapat memanfaatkan teknologi ini sepenuhnya dalam melindungi tanaman mereka.
Dari sudut keselamatan makanan, penggunaan Metarhizium memberikan nafas baru kepada konsep pertanian lestari di Malaysia. Memandangkan ia adalah organisma hidup yang tidak mengandungi bahan kimia toksik, tanaman yang dirawat dengan kulat ini tidak mempunyai tempoh dilarang tuai yang lama. Petani boleh memetik hasil tanpa bimbang tentang baki racun yang sering menjadi isu dalam pensijilan MyGAP (Malaysian Good Agricultural Practices). Selain itu, penggunaan biopestisid ini secara berpanjangan dapat memulihkan populasi serangga bermanfaat seperti lebah dan labah-labah pemangsa yang sering terbunuh akibat penggunaan racun kimia spektrum luas. Ini secara tidak langsung mengembalikan keseimbangan ekologi di kawasan pertanian kita.
Satu lagi kelebihan utama Metarhizium adalah kemampuannya untuk mengatasi isu kerintangan atau “kekebalan” perosak. Masalah utama racun kimia adalah kecenderungan serangga untuk membina daya tahan genetik terhadap bahan aktif tertentu. Walau bagaimanapun, sukar bagi serangga untuk membina pertahanan terhadap serangan fizikal dan pelbagai enzim yang dikeluarkan oleh kulat ini. Kajian di lapangan menunjukkan bahawa penggunaan Metarhizium bukan sahaja membunuh perosak dewasa, tetapi juga mampu menjangkiti peringkat larva dan pupa di dalam tanah, memberikan perlindungan menyeluruh dari akar hingga ke pucuk tanaman.
Dari sudut kelestarian alam sekitar, Metarhizium tidak membahayakan serangga bermanfaat seperti lebah pendebunga atau kelulut. Ini membolehkan ekosistem ladang berfungsi secara lebih harmoni. Transformasi ke arah penggunaan biopestisid seperti Metarhizium bukan sahaja langkah bijak untuk kesihatan tanaman, tetapi juga sebagai persediaan petani menghadapi cabaran perubahan iklim yang sering menyebabkan ledakan populasi perosak secara mendadak.
Secara keseluruhannya, aplikasi Metarhizium dalam pengurusan perosak adalah langkah bijak ke arah masa depan pertanian lestari di negara ini. Walaupun ia memerlukan sedikit pemahaman teknikal mengenai waktu semburan dan penjagaan kelembapan, manfaat jangka panjangnya jauh mengatasi penggunaan racun kimia konvensional. Dengan sokongan berterusan daripada penyelidikan tempatan dan kesedaran petani yang semakin tinggi, kulat ini bakal mengubah cara kita menghasilkan makanan. Metarhizium membuktikan bahawa penyelesaian terbaik bagi masalah pertanian masa kini sebenarnya sudah sedia ada di dalam persekitaran kita sendiri, hanya menunggu untuk dimanfaatkan demi kesejahteraan manusia dan alam sekitar.
Rujukan:
- Saranum, M. M., Jamil, S. F., Lim, S. H. J., Mohd Sufian, S. N. H., & Mohd Suhaimi, M. S. (2022). Potential of entomopathogenic fungi to control new invasive pests Spodoptera frugiperda on maize. Transactions of the Malaysian Society of Plant Physiology, 29, 86–89.
- Wan Muhammad Azrul, W. A., Suhana, Y., Hanis Aifa, A., Nur Farhanah, I., Zulaikha, M., Siti Ilyani, A., Mohd Saidi, Z., & Rozeita, L. (2025, September). Dual function of Metarhizium: Entomopathogenic activity and nutritional quality improvement in Chinese cabbage. Paper presented at the 6th International Symposium on Insects (ISOI 2025), Terengganu, Malaysia.
Biodata Penulis:
Wan Muhammad Azrul bin Wan Azhar merupakan seorang Pegawai Penyelidik di MARDI di dalam bidang pengurusan perosak dan penyakit tanaman. Penyelidikannya tertumpu kepada pembangunan teknologi kawalan biologi, dengan fokus utama kepada penggunaan kulat entomopatogenik sebagai alternatif kepada racun kimia sintetik serta kaedah Pengurusan Perosak Bersepadu (Integrated Pest Management, IPM) dalam menghasilkan penyelesaian perlindungan tanaman yang mesra alam.